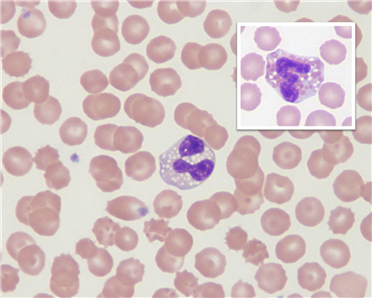
20180307_3ab776b00f2f2763eedee74d5008613a.png

견계의 '산소탱크' 그레이하운드

사람들 모두 알고 있는 것처럼, 강아지는 각 견종별로 고유한 신체적 특징을 가지고 있습니다.
어떤 종은 짧은 다리를, 어떤 종은 긴 주둥이를, 어떤 종은 접힌 귀를 가지고 있지요.
개체 차이는 있지만, 이러한 견종들 사이에는 성격 차이도 있다고 여겨집니다.

일반적으로 활달하다거나, 영리하다거나, 차분하다거나 신경질적이라거나 하는 묘사가 동원되기도 합니다.
그 외에 다른 특징은 없을까요? 드러나지 않은 부분에서 차이가 나타나기도 합니다.
예를 들어 경주견으로 유명한 그레이하운드를 살펴보겠습니다.
 사진=shutterstock(이하)
사진=shutterstock(이하)그레이하운드는 유선형의 몸체와 가는 허리, 강한 다리를 가진 것으로 잘 알려진 개입니다.
관련한 수의학적 연구를 살펴보면 이들은 대체로 일반적인 강아지들보다 헤모글로빈 수치가 높으며, 적혈구의 절대 숫자도 많고, 적혈구 용적 백분율 (packed cell volume, 전체 혈액에서 적혈구가 차지하는 용적) 역시 높은 것으로 나타납니다.

적혈구가 많으면 체내의 산소 운반능력이 향상되고, 온몸에 지속적으로 산소가 공급되어야 하는 (지구력이 필요한) 운동능력이 향상됩니다.

그래서 어떤 운동선수들은 적혈구의 생성을 촉진하기 위해 에리스로포이에틴(EPO)이라고 하는 불법 약물을 사용하다가 적발되기도 하지요.
반면에 그레이하운드는 원래부터 적혈구가 많으니, 그야말로 뼛속... 아니 '핏속까지' 운동선수라고 할 수 있습니다.

그러니 미국의 장거리 버스 회사 이름이 그레이하운드인 것도 우연이 아닙니다.
여기서 끝이냐고요? 그레이하운드의 이름값은 운동능력 정도로는 그치지 않아서 심지어 혈중에 회색 백혈구가 나타날 때도 있는데요.

이게 무슨 말인가 하면 이렇습니다. 사람처럼 동물도 혈액 샘플을 채취해서 염색의 과정을 거친 뒤, 현미경으로 직접 관찰하게 되면 적혈구, 백혈구, 혈소판을 구분해서 볼 수 있는데요.
이때 호산구(백혈구의 일종)들은 일반적인 상황에서는 공포(Vacuolate, 빈 주머니)를 거의 형성하지 않습니다.
그런데 그레이하운드의 경우 약 절반가량은 호산구가 다수의 공포를 가지고 있어서 염색상 회색으로 관찰되는 경우가 있고, 이것을 학자들은 Grey Eosinophils (회색 호산구)라고 부릅니다.
회색 호산구의 사진. 오른쪽 위는 비교를 위해 삽입한 일반적인 개의 호산구 사진입니다. (출처 : www.eclinpath.com)
회색 호산구의 사진. 오른쪽 위는 비교를 위해 삽입한 일반적인 개의 호산구 사진입니다. (출처 : www.eclinpath.com)현미경 소견상 세포들에서 이러한 변형이 발견되면 원칙적으로 비정상으로 간주하지만, 그레이하운드의 회색 호산구는 세포의 전체적인 물리화학적 구조나 기능적인 측면에서 일반적인 호산구와 동일합니다.
그래서 수의학적으로 아주 중요한 내용은 아니지만 그레이하운드의 이름값 하는 소견(...) 정도로 알면 참고가 된다고 할 수 있습니다.

※ 본 콘텐츠는 양이삭 수의사(yes973@naver.com)가 노트펫에 기고한 칼럼을 바탕으로 작성되었습니다.
에디터 김승연 <ksy616@inbnet.co.kr>